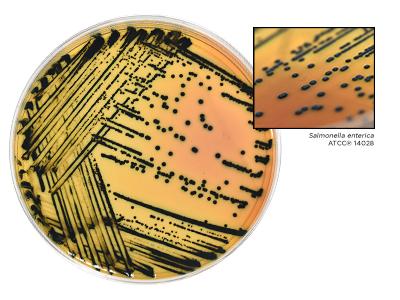
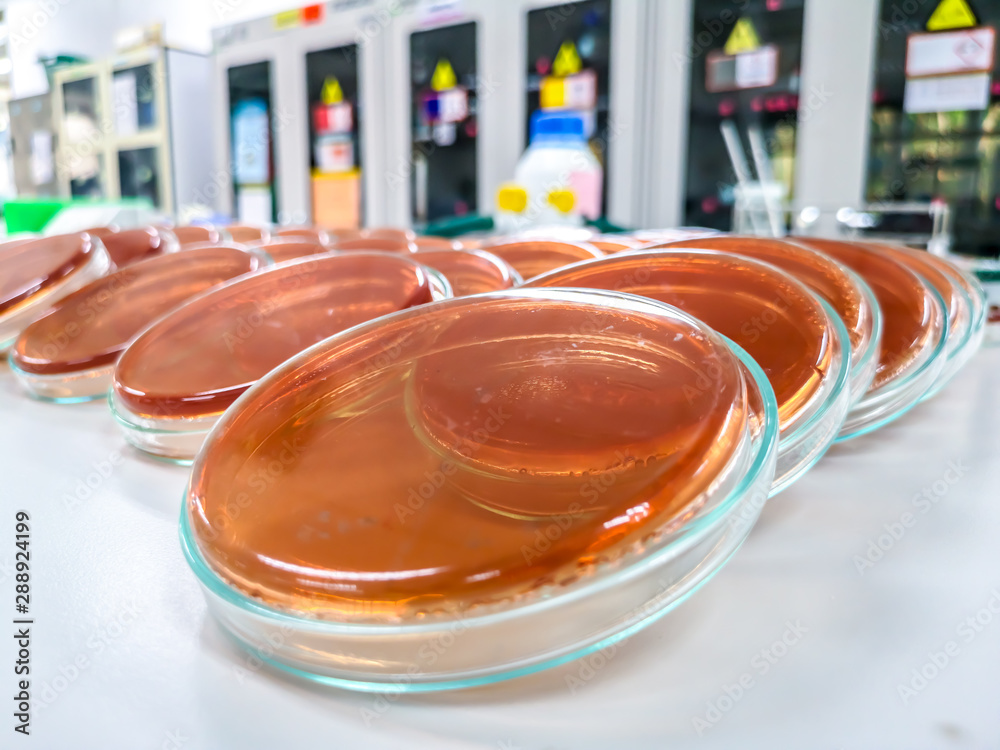

S s агар
S s агар 138 фотографий
Ниссан серена неисправности
Веселая история маленький
Расписание 418 ая горно алтайск
Погода в монделево гатчинский
Не удается добавить аккаунт стим гуард
Элегра автозавод
Полиграфистов 3
Санаторий заря подмосковье отзывы
Вес кузова 2106
Автоград калуга тульское шоссе 14